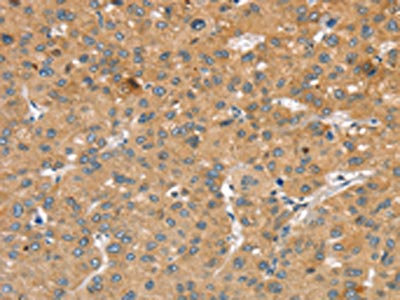

SLIT2 Antibody
-
中文名稱:SLIT2兔多克隆抗體
-
貨號(hào):CSB-PA136864
-
規(guī)格:¥1100
-
圖片:
-
The image on the left is immunohistochemistry of paraffin-embedded Human liver cancer tissue using CSB-PA136864(SLIT2 Antibody) at dilution 1/30, on the right is treated with synthetic peptide. (Original magnification: ×200)
-
The image on the left is immunohistochemistry of paraffin-embedded Human colon cancer tissue using CSB-PA136864(SLIT2 Antibody) at dilution 1/30, on the right is treated with synthetic peptide. (Original magnification: ×200)
-
Gel: 6%SDS-PAGE, Lysate: 40 μg, Lane: Mouse bladder tissue, Primary antibody: CSB-PA136864(SLIT2 Antibody) at dilution 1/200, Secondary antibody: Goat anti rabbit IgG at 1/8000 dilution, Exposure time: 1 minute
-
-
其他:
產(chǎn)品詳情
-
Uniprot No.:
-
基因名:
-
別名:Drad 1 antibody; E030015M03Rik antibody; E130320P19Rik antibody; FLJ14420 antibody; OTTHUMP00000158695 antibody; OTTHUMP00000217852 antibody; OTTHUMP00000217853 antibody; OTTHUMP00000217854 antibody; Slil 3 antibody; Slil3 antibody; Slit 2 antibody; Slit homolog 2 (Drosophila) antibody; Slit homolog 2 antibody; Slit homolog 2 protein antibody; Slit homolog 2 protein C-product antibody; Slit-2 antibody; Slit2 antibody; SLIT2_HUMAN antibody
-
宿主:Rabbit
-
反應(yīng)種屬:Human,Mouse,Rat
-
免疫原:Synthetic peptide of Human SLIT2
-
免疫原種屬:Homo sapiens (Human)
-
標(biāo)記方式:Non-conjugated
-
抗體亞型:IgG
-
純化方式:Antigen affinity purification
-
濃度:It differs from different batches. Please contact us to confirm it.
-
保存緩沖液:-20°C, pH7.4 PBS, 0.05% NaN3, 40% Glycerol
-
產(chǎn)品提供形式:Liquid
-
應(yīng)用范圍:ELISA,WB,IHC
-
推薦稀釋比:
Application Recommended Dilution ELISA 1:1000-1:2000 WB 1:200-1:1000 IHC 1:25-1:100 -
Protocols:
-
儲(chǔ)存條件:Upon receipt, store at -20°C or -80°C. Avoid repeated freeze.
-
貨期:Basically, we can dispatch the products out in 1-3 working days after receiving your orders. Delivery time maybe differs from different purchasing way or location, please kindly consult your local distributors for specific delivery time.
-
用途:For Research Use Only. Not for use in diagnostic or therapeutic procedures.
相關(guān)產(chǎn)品
靶點(diǎn)詳情
-
功能:Thought to act as molecular guidance cue in cellular migration, and function appears to be mediated by interaction with roundabout homolog receptors. During neural development involved in axonal navigation at the ventral midline of the neural tube and projection of axons to different regions. SLIT1 and SLIT2 seem to be essential for midline guidance in the forebrain by acting as repulsive signal preventing inappropriate midline crossing by axons projecting from the olfactory bulb. In spinal chord development may play a role in guiding commissural axons once they reached the floor plate by modulating the response to netrin. In vitro, silences the attractive effect of NTN1 but not its growth-stimulatory effect and silencing requires the formation of a ROBO1-DCC complex. May be implicated in spinal chord midline post-crossing axon repulsion. In vitro, only commissural axons that crossed the midline responded to SLIT2. In the developing visual system appears to function as repellent for retinal ganglion axons by providing a repulsion that directs these axons along their appropriate paths prior to, and after passage through, the optic chiasm. In vitro, collapses and repels retinal ganglion cell growth cones. Seems to play a role in branching and arborization of CNS sensory axons, and in neuronal cell migration. In vitro, Slit homolog 2 protein N-product, but not Slit homolog 2 protein C-product, repels olfactory bulb (OB) but not dorsal root ganglia (DRG) axons, induces OB growth cones collapse and induces branching of DRG axons. Seems to be involved in regulating leukocyte migration.
-
基因功能參考文獻(xiàn):
- SLIT2/ROBO1 signalling may regulate trophoblast differentiation and invasion causing restricting beta human chorionic gonadotrophin (beta-hCG) production, shallow trophoblast invasion and inhibiting placental angiogenesis in missed and threatened miscarriage during the first trimester. PMID: 28485101
- The findings indicate that the migration of human neural progenitor cells from the fetal subventricular zone to the olfactory bulb is partially regulated by the Slit2-Robo1 axis. PMID: 28406573
- Elevated SLIT2 promoter methylation contributed to the risk of NPC. PMID: 29107007
- The alteration of Slit2 and Robo1 expression in the retinas of diabetic rats and patients with proliferative diabetic retinopathy suggests a role for the Slit-Robo signal in the various stages diabetic retinopathy. PMID: 28973045
- human placental multipotent mesenchymal stromal cell express Slit2 and both Robo1 and Robo4 are present in human umbilical vein endothelial cells. PMID: 26745454
- Slit2-Robo1 signaling promoted the adhesion, invasion and migration of tongue carcinoma cells by upregulating the expression levels of MMP2 and MMP9 and, downregulating the expression of E-cadherin. PMID: 27431199
- findings suggest that AK3 and SLIT2 may be potential candidates involved in genetic susceptibility to colorectal cancer PMID: 27888432
- Low Slit2 expression is associated with glioma. PMID: 27916173
- Results indicate the importance of SLIT2-ROBO1-CDC42 signaling pathway in predicting tumor progression. PMID: 27659325
- We postulate that Robo1 promotes tumor invasion partly by the upregulation of MMP2 after activation of PI3K/Akt signaling pathway. Notably, Slit2 knockdown caused the upregulation of Robo1 expression both at the mRNA and protein levels. Thus, the stimulatory effects of Slit2 knockdown on tumor progression can be ascribed, at least in part, to the upregulation of Robo1 and its positive role in tumor progression. PMID: 27176045
- expression of the evolutionarily conserved slit2 Gene Promoter Requires Sp1 PMID: 26456684
- Study shows that Slit2 mRNA and protein levels were significantly reduced in papillary thyroid cancer (PTC) specimens and implicates Slit2 functions as a negative regulator in the development and progression of PTC. PMID: 26935705
- Overexpression of Slit2 induces its tumor suppressive effects in Breast cancer. PMID: 26542734
- Significantly increased serum Slit2 levels and hepatic expression of Slit2 and Robo1 were observed in patients with liver fibrosis. PMID: 26264936
- temporary up-regulation in remodeling vessel and down-regulation in remodeled vessel of polygonal-shape extravillous trophoblast cells occurred in tubal pregnancies PMID: 26282852
- our findings indicated that Slit2/Robo1 axis possibly be regarded as a significant clinical parameter for predicting brain metastasis in breast cancer patients. PMID: 26400100
- These results suggest that Slit2/Robo1 binding exerts an effect on cell migration, which is negatively regulated by Robo4, and Robo1 may function by interacting with CdGAP in HUVECs. PMID: 26713366
- VEGFR2 activation was not affected by Slit2, but eNOS phosphorylation was diminished PMID: 26002231
- Slit2-exon 15 splicing variants have different roles in angiogenesis and HUVEC permeability PMID: 26021305
- Data indicate that SLIT2, miR-218-1, RET/PLAG1 and SLIT2/ROBO1 pathway involved in Hirschsprung's disease. PMID: 25786906
- Slit2/Robo1 signaling promotes intestinal tumorigenesis through Src-mediated activation of the Wnt/beta-catenin pathway. PMID: 25605242
- In this review, we summarize recent findings demonstrating that the neuronal guidance cues, Slit and Roundabout (Robo), prevent the migration of multiple leukocyte subsets towards diverse inflammatory chemoattractants. PMID: 24777535
- Inactivation of SLIT2 and/or ROBO1 is one of the early events in development of dysplastic lesions of head and neck and has prognostic importance. PMID: 25465073
- Results provide novel evidence that low expression of SLIT2 correlates with poor prognosis and promotes metastasis in ESCC, which may be regulated by the Cdc42-mediated pathways. PMID: 25490006
- SLIT2 expression and cancer-associated fibroblasts are correlated with neural remodeling. PMID: 25590802
- Mutations of the SLIT2-ROBO2 pathway genes SLIT2 and SRGAP1 confer risk for congenital anomalies of the kidney and urinary tract PMID: 26026792
- Slit2 is decreased in human myometrium after labor and knock-down studies describe an anti-inflammatory effect of Slit2 in myometrial cells. PMID: 25130654
- reduced expression in obese placenta and in primary trophoblast cells treated with pro-inflammatory mediators IL-1beta, TNF-alpha and LPS PMID: 25329354
- These findings of this study demonstrated that Slit2 overexpression may be responsible for AD-like alterations and the increased BBB permeability in these mice PMID: 25114073
- PDGFD, CDH1 and SLIT2 are upregulated in low grade meningiomas and schwannomas compared with healthy tissue. PMID: 25333347
- Data show that ubiquitin specific peptidase 33 (USP33) mediates nerve tissue proteins Slit-Robo signaling in lung cancer cell migration. PMID: 24981056
- data may explain why fibrocytes are rarely observed in healthy tissues, may suggest that the relative levels of Slit2 present in healthy tissue and at sites of fibrosis may have significant effect on decision of monocytes to differentiate into fibrocytes PMID: 25489114
- Results suggest that Slit2 might be involved in skin tumorigenesis. PMID: 24840330
- Slit2 knockdown promotes gastric cancer growth and metastasis through activation of the AKT/betacatenin-mediated signaling pathway. PMID: 24297051
- Biological activity of Slit2 and its binding to Robo1 have no affect on the dimer formation of Robo1. PMID: 24673457
- Slit2 is downregulated in renal cell carcinoma and may have a role as a tumor suppressor PMID: 24287947
- Slit2 overexpression increases the lesion size in endometriosis and increases microvessel density. PMID: 22875847
- An N-terminal SLIT2 cleavage fragment stimulated such migration. PMID: 24448236
- Slit2 was highly expressed in gastric cancer patients with less advanced clinicopathological features. Slit2 levels were correlated with beta-catenin level and subcellular localization. PMID: 23933755
- SLIT2 suppresses colon tumor metastasis, and it exerts its suppressive activity against colorectal cancer metastasis by restraining AKT-GSK3beta signaling. PMID: 23314850
- Slit2-Robo4 is a key regulator of endothelial inflammation, and its dysregulation during endotoxemia is a novel mechanism for LPS-induced vascular pathogenesis. PMID: 24272999
- Hypermethylation of SLIT2 is associated with colorectal cancer. PMID: 23694962
- Slit2 inhibits Andes virus and Hantaan virus induced permeability and adherens junctions disassembly of pulmonary microvascular endothelial cells by interactions with Robo4 PMID: 23702092
- hypomethylation of LINE-1 and hypermethylation of SLIT2, MAL and IGFBP7 were frequently detected in NSCLCs and associated with various clinical features. PMID: 23381221
- Methylation of SLIT2 gene is associated with colorectal neoplasia in ulcerative colitis and Crohn's colitis. PMID: 22532293
- Loss of expression of SLIT2 by promoter hypermethylation and loss of heterozygosity events is significantly associated with serrated adenoma development PMID: 23671423
- N-terminal of Slit2 inhibits HIV-1 replication by regulating the actin cytoskeleton PMID: 23294842
- Promoter methylation status analysis of hereditary breast tumors revealed high methylation frequencies for the three genes (67% RASSF1A, 80% SLIT2, and 72% WIF1). PMID: 22315090
- Silencing of miRNA-218 promotes migration and invasion of breast cancer via Slit2-Robo1 pathway PMID: 22898079
- The cell motility modulator Slit2 is a potent inhibitor of platelet function. PMID: 22865890
顯示更多
收起更多
-
亞細(xì)胞定位:Secreted. Note=The C-terminal cleavage protein is more diffusible than the larger N-terminal protein that is more tightly cell associated.
-
組織特異性:Fetal lung and kidney, and adult spinal cord. Weak expression in adult adrenal gland, thyroid, trachea and other tissues examined.
-
數(shù)據(jù)庫(kù)鏈接:
Most popular with customers
-
-
YWHAB Recombinant Monoclonal Antibody
Applications: ELISA, WB, IHC, IF, FC
Species Reactivity: Human, Mouse, Rat
-
Phospho-YAP1 (S127) Recombinant Monoclonal Antibody
Applications: ELISA, WB, IHC
Species Reactivity: Human
-
-
-
-
-